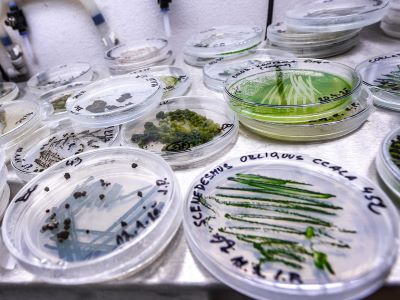
microalgae-biomass-2-hp

Bio2AgroFood PROJEKT
Einsatz nachhaltiger Biotechnologie im Agrar- und Lebensmittelsektor
Mikroalgen in einer Petrischale
Foto: Algatech

Mikroalgenextrakte
Foto: Melanie Wallner

Brot mit Mikroalgen
Foto: Melanie Wallner
Das Interreg-Projekt Bio2AgroFood (2025-2027) konzentriert sich auf die Anwendung von Mikroalgen in Lebensmitteln, Futtermitteln und regional wichtigen Getreidearten. Dieses grenzüberschreitende Forschungsprojekt profitiert vom Fachwissen und den Kenntnissen des Instituts für Mikrobiologie (MBU, Trebon, Tschechien), der Fachhochschule Oberösterreich (Wels, Österreich) und des österreichischen Kompetenzzentrums für Futter- und Lebensmittelqualität, -sicherheit und -innovation (FFoQSI, Tulln).
Das Projekt zielt darauf ab, neue Lösungen für die Herstellung von funktionellen Lebens- und Futtermitteln durch regionale Unternehmen sowie für die Verwendung von Mikroalgen bei der Herstellung von Biostimulanzien/Bioziden für Nutzpflanzen wie Weizen, Gerste und Mohn zu finden. Darüber hinaus soll das Projekt die Zusammenarbeit zwischen den Partnern stärken und damit die regionale Wettbewerbsfähigkeit in Forschung und Entwicklung steigern.
Lebensmittelunternehmen sind an neuen funktionellen Lebensmitteln interessiert, die mit mehrfach ungesättigten Fettsäuren (PUFAs), insbesondere Omega-3-Fettsäuren, angereichert sind, an denen es in der Ernährung mangelt. Darüber hinaus verlangen Futtermittelhersteller nach Produkten, die die Gesundheit und Leistungsfähigkeit von Nutztieren durch Unterstützung der Darmgesundheit und der Darmflora verbessern. Da die Nachfrage nach Biostimulanzien/Biozide natürlichem Ursprungs unter Landwirten steigt, befasst sich das Projekt auch mit der Anwendung von Mikroalgen für den Anbau regional wichtiger Nutzpflanzen wie Weizen, Gerste und Mohn.
Mikroalgen stellen eine wertvolle Gruppe an Mikroorganismen dar, die Substanzen produzieren, welche für die Ernährung von Mensch und Tier sowie für die Landwirtschaft von Bedeutung sind. Dabei handelt es sich unter anderem um mehrfach ungesättigte Fettsäuren (PUFA) und Pigmente wie Lutein, die sowohl für die Lebensmittel- als auch für die Futtermittelproduktion von besonderem Interesse sind. Darüber hinaus haben primäre und sekundäre Algenmetaboliten das Potenzial, präbiotische, entzündungshemmende und die Darmbarriere stärkende Wirkungen zu entfalten. Ebenso wurde gezeigt, dass bestimmte Mikroalgenstämme Phytohormone und antimikrobielle Komponenten produzieren, was sie zu interessanten Kandidaten für die Herstellung von Biostimulanzien und Biopestiziden macht. Während die Wirkungen dieser Substanzen bereits wissenschaftlich beschrieben wurden, sind die Technologien für ihre Extraktion und Verarbeitung für den kommerziellen Einsatz noch unterentwickelt.
Zu den Projektergebnissen zählen neue oder verbesserte Anbautechnologien, die Verarbeitung von Biomasse und die Nutzung wertvoller Verbindungen, die in Standardarbeitsanweisungen (SOPs) beschrieben und anhand von Funktionsmustern demonstriert werden. Diese Technologien werden im Rahmen gemeinsamer Forschungs- und Entwicklungsarbeiten entwickelt und in Zusammenarbeit mit KMU in realen Umgebungen getestet. Am Ende des Projekts werden die Ergebnisse gemäß der europäischen Gesetzgebung (GBER) und des EU-Rahmens für staatliche Beihilfen für Forschung und Entwicklung ohne zusätzliche gesetzliche Beschränkungen sofort für die Kommerzialisierung verfügbar sein.
Projektinformationen
- Registrierungsnummer: ATCZ00171
- Förderschiene: Interreg AT-CZ 2021–2027
- Laufzeit: 2025–2027
- Gesamtfördersumme (€): 764.773,53
Projektpartner
- Institut für Mikrobiologie CAS, v. v. i. – Centre Algatech, Třeboň (Leading partner)
- FH OÖ Forschungs & Entwicklungs GmbH, Wels
- Austrian Competence Centre for Feed and Food Quality, Safety & Innovation (FFoQSI), Tulln

Lead Researcher: 
FH-Prof. Priv.-Doz. Dr. Julian Weghuber
FFoQSI Area Leader GREEN
Leiter CoE Lebensmitteltechnologie und Ernährung
Lebensmitteltechnologie und Ernährung an der FH Oberösterreich
julian.weghuber@fh-wels.at
+43 5 0804 44403
www.fh-ooe.at
Project Leader:

Melanie Wallner MSc
Bio2AgroFood Projektkoordinatorin & Research Associate
melanie.wallner@ffoqsi.at
+43 5 0804 48859
www.ffoqsi.at


